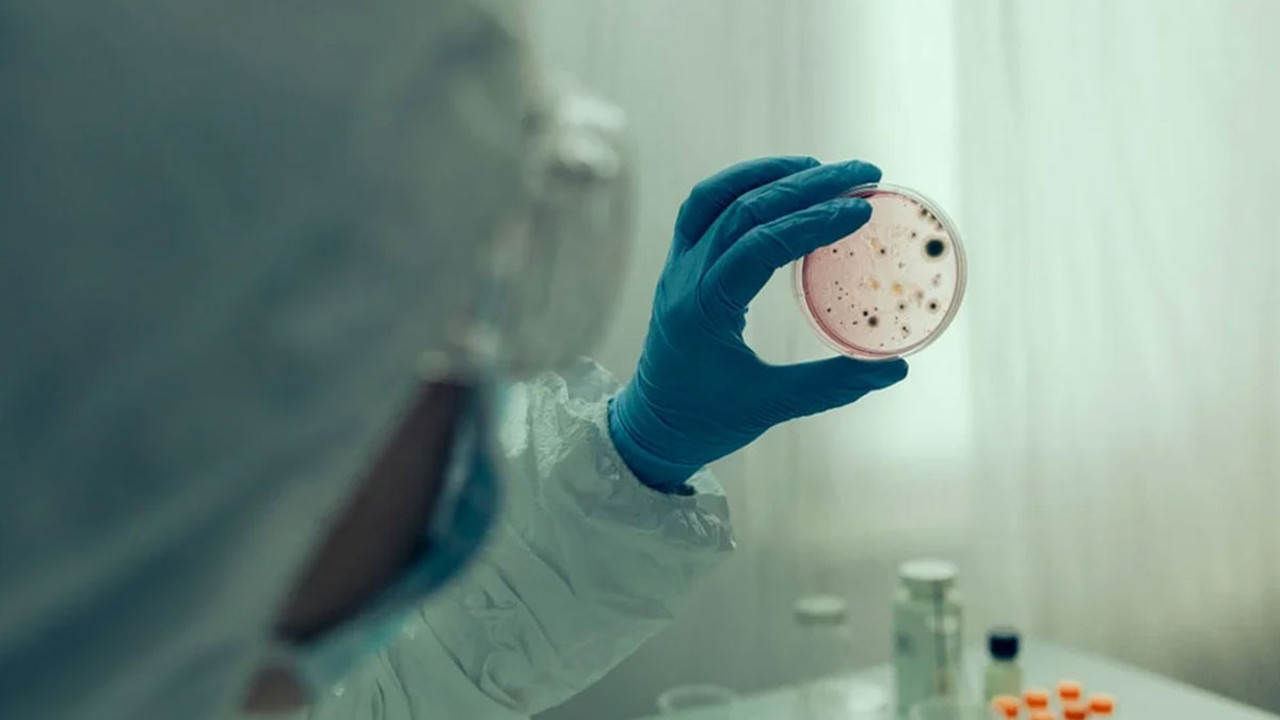
DSÖ'den salgın alarmı! Sudan bulaşıyor, ölüme götürüyor

Dünya Sağlık Örgütü (DSÖ), dünya genelinde kolera vakalarının yayıldığını ve ölüm oranlarının yükseldiğini bildirdi.
DSÖ tarafından yayımlanan raporda, şu anda 31 ülkede salgın yaşandığı ve 4 bin 738 kişinin kolera nedeniyle hayatını kaybettiği belirtildi.
"YAYILMA RİSKİ ÇOK YÜKSEK"
Raporda, "Salgınların ölçeği ve birbirine bağlı yapısı göz önüne alındığında, ülkeler içinde ve arasında daha fazla yayılma riski çok yüksek" ifadeleri kullanıldı.

DSÖ, salgınlardaki artışın en önemli nedenlerini çatışmalar, yoksulluk ve altyapı yetersizliği olarak sıraladı. Özellikle kırsal bölgeler ve sel felaketlerinden etkilenen yerlerde riskin daha yüksek olduğunun altı çizildi.
DSÖ, ülkeleri acil önlem almaya ve temiz su, hijyen altyapısını güçlendirmeye çağırdı.